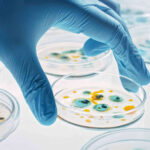

Plataforma experimental esconde vírus dentro de bactérias para atacar tumores e driblar o sistema imunológico
Pesquisadores da Columbia Engineering desenvolveram uma terapia inovadora que faz bactérias e vírus trabalharem juntos para atacar tumores.
O estudo, publicado na Nature Biomedical Engineering, apresenta o sistema CAPPSID (Coordinated Activity of Prokaryotes and Picornavirus for Safe Intracellular Delivery), que esconde vírus dentro de bactérias capazes de localizar tumores, contornar o sistema imunológico e liberar o vírus diretamente nas células cancerígenas.

Detalhes do estudo
- A estratégia combina a tendência da bactéria Salmonella typhimurium de migrar para o interior de tumores com a capacidade natural do vírus de infectar e matar células cancerígenas.
- “As bactérias atuam como um cavalo de Troia, transportando o RNA viral para dentro do tumor, onde se rompem e liberam o vírus”, explica o coautor Zakary Singer.
- Um dos maiores avanços é superar a barreira do sistema imunológico, que normalmente neutraliza vírus terapêuticos em pacientes já expostos a eles.
- Ao “esconder” o vírus dentro da bactéria, os anticorpos não conseguem interceptá-lo antes de chegar ao tumor.
Leia mais:

Para evitar riscos de infecção descontrolada, os cientistas projetaram o vírus para depender de uma molécula produzida apenas pelas bactérias dentro do tumor, o que impede sua disseminação em tecidos saudáveis.
Passos futuros
Validada em testes com camundongos, a tecnologia representa o primeiro exemplo de cooperação projetada entre bactérias e vírus no combate ao câncer. Os pesquisadores já solicitaram patente e estudam ampliar a plataforma para diferentes tipos de tumores, visando futuras aplicações clínicas.

Colaboração para o Olhar Digital
Leandro Criscuolo é jornalista formado pela Faculdade Cásper Líbero. Já atuou como copywriter, analista de marketing digital e gestor de redes sociais. Atualmente, escreve para o Olhar Digital.
Descubra mais sobre Euclides Diário
Assine para receber nossas notícias mais recentes por e-mail.